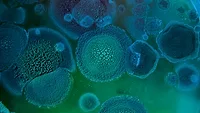
mold spores mold spores

Bedbugs and Mental Health
A call for help may mean more than remediation


When I was approached about addressing the topic of bedbugs for this issue of R&R, I instantly knew I wanted to put product and remediation talk aside. This article has a very difference focus that in many ways is more important.
The office staff at Noble Pine has morphed into junior psychologists and private detectives. When we receive a telephone call from someone who wants to buy Sterifab, we have become accustomed to hearing about their specific bedbug concerns.
After numerous symposiums, seminars, and repetitive lectures, one can recite the complete evolutionary path of the bedbug, its eating and intercourse habits, and where it prefers to hide from its next victims. The speakers are armed with statistics about this tenacious insect’s habits and lifestyles, genetic make-up, and more. One topic always touched upon is the mental anguish bedbug victims suffer. Sadly, “touched on” is as far as it gets. They don’t dwell on the psychosis, depression or anxiety that many people end up suffering. As restorers, it is important for you to understand what your client might be dealing with as you start remediation.
Scores and scores of stories appear weekly, yet bedbugs are unlike other insects. Along with a rash often come anxiety issues. Some people become so overwhelmed that serious emotional problems have been reported to us.
We often receive calls about fleas, ticks, silverfish, roaches and more, but people don’t seem to become despondent about these insects as they do with bedbugs.
If you have fleas or ticks, it just means your dog or cat that picked them up outside of the house.
If you find silverfish in your home, you may be keeping your firewood too close to the house.
Cockroaches? A more common problem in apartments, but their occurrence often occurs by bringing them in in supermarket paper bags, or from a neighbor’s dwellings.
But bedbugs? What is wrong with me? The stigma that a bedbug infestation inflicts upon many is overwhelmingly emotional.
Let me touch upon a few of these situations and try not to be boring at your expense or sarcastic about theirs.
Situation #1: Her Half, Not His?
A woman called about being bitten in bed. She seemed well aware of the bedbug’s biology, so I didn’t attempt to offer a primer in regard to the life cycle of a bedbug. She told me how she would wake up at night, then find blood spots on her sheets in the morning. We asked the usual questions…
- Did you also see brown spots in addition to the blood?
- Have you looked around the room for any bedbug harborages, like behind picture frames, headboards or lampshades?
- Do you have any rash or bite marks?
The answer was “yes” for the rash and brown spots, but “no” she hadn’t found evidence of harborages (where they gather).
“Are you sure about this?” I asked in an understanding tone.
The strange part of this case was that according to her, she was the only one in this marriage getting bitten, not her husband who slept next to her in the same bed! And, all the evidence was only on her side of the bed. As I mentioned, we listened, we didn’t judge.
This scenario didn’t seem possible according to the bedbug pundits who do all the lecturing, but we just listen. Could it be that husband and wife use different deodorants? I never did get a definitive answer. We advised her to spray both halves of the bed with Sterifab along with the rest of the bedbug eviction protocol.
She was one of the first “slightly troubled” callers I remember. It was like an introduction to the head games that bedbug problems create for people, and the appetizer for more difficult problems yet to come.
Situation #2: Delusional Parasitosis
Another call sounded much more serious. Only days before, I read about a condition called delusional parasitosis. People think they are being invaded or living with all kinds of insects, bacteria, and germs. I now answer a call from a woman who has bedbugs and germs, mildew and more in her home. She had tried every product on the market to eradicate these multiple bugs and bacteria, but nothing had worked, and her phone call was apparently her last resort. She was absolutely frantic and beyond desperation.
After a 15 minute conversation, she seemed eager to try Sterifab, though more importantly, after some calming down, she agreed to schedule some time with a therapist. I thought it better to coax her into some serious counseling rather than spray for bugs that might not even be there.
As I thought back on the conversation, I remembered her weepy voice and plaintive tone. How many people had she told this story to who wouldn’t listen? How many that she would resort to pouring her heart out to a perfect stranger? How sad.
Situation 3: An Exhausting Routine
Let me offer one additional story. A family seemed to have the whole problem of bedbugs solved. The man told us that after dealing with five episodes of bedbugs, they had a routine figured out. They had spent a small fortune on pest control professionals, only to have the bedbugs keep coming back. I interrupted his story several times to suggest that the exterminators might not have gotten all the unhatched bedbug eggs vacuumed up……but I guess we were already on the same page.
Every night before they went to bed, they performed a thorough house cleaning that included vacuuming closets, and every drawer in every clothing chest in every room. They then discarded the vacuum bag which they were convinced was full of bedbug eggs. They were evidently resigned to this regimen forever. No more exterminators, no more sprays, no more advice. I suggested that at some point, a professional should be able to tell him that the bugs could very well be gone, but he said this is how they will continue to live.
Understanding the Stigma
We had an ex-employee call to tell us he found bedbugs in his apartment. He asked if we could help him out with a bottle of Sterifab for old times’ sake. We said sure. I suggested that he meet me across the street from our factory. I’d walk over and hand it to him. I also asked, (perhaps pleaded) that he not come in our building. As a matter of fact, maybe we should meet in a big parking lot, and I’ll tell you the number of the parking spot I left the package…….D47, OK? Poor Bob…..he said to me, “Do you know how tired I am of all these sick jokes?”
I gather his thoughts are similar to what someone goes through when they have bedbugs. We’ve all learned over time that you have to be patient and caring when “they” call. Helpful, yet understanding.
As I approach the end of this piece, it’s a Sunday night and I’m saying to myself that we’ll have lots of orders to process tomorrow….another day at the office. But I’m also thinking, how long after we turn on the lights will that the first frantic phone call come in? Be compassionate, be understanding.
Looking for a reprint of this article?
From high-res PDFs to custom plaques, order your copy today!